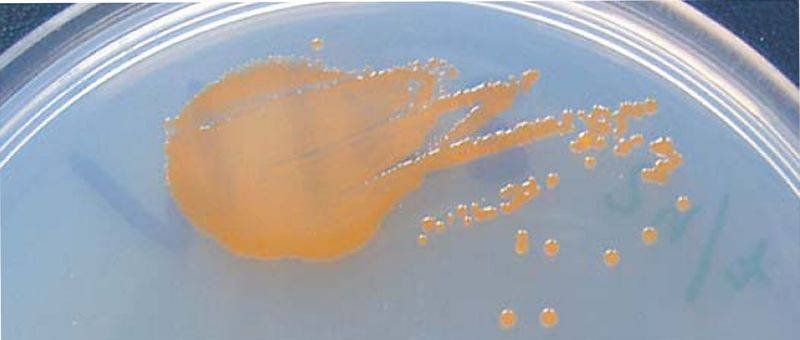

Este curso académico, y gracias a la colaboración de la Consejería de Empleo, Políticas Sociales y Vivienda del Gobierno de Canarias, la Universidad de La Laguna ha convocado la primera edición de los Premios a la Solidaridad y el Voluntariado, cuyo fallo se dio a conocer ayer jueves 15 en el transcurso de la celebración del Concierto de Navidad de la institución académica
El premio tiene una finalidad eminente social, al tratar de difundir la idea de que el voluntariado es un medio para colaborar en la solución de las problemáticas sociales, y que todos estamos llamados a dedicar parte de nuestro tiempo a la comunidad. En esta primera convocatoria se han contemplado dos modalidades. La primera tiene que ver con vídeos creativos, y reconoce la creación de una pieza audiovisual original que haga referencia algunas de las actividades o campañas organizadas por asociaciones solidarias o colectivos universitarios, mientras que la segunda se ciñe a Trabajos de Fin de Grado (TFG) y Fin de Máster (TFM) que destaquen por su excelencia, rigor, originalidad, o bien por su carácter innovador en el ámbito de la solidaridad y el voluntariado.
En la entrega de los premios en el Paraninfo estuvieron presentes tanto el rector de la institución académica, Antonio Martinón, como la directora general de Políticas Sociales e Inmigración del Gobierno de Canarias, Carmen Acosta, así como el alcalde de La Laguna, José Alberto Díaz.
Así, el jurado de la modalidad de videos creativos decidió por unanimidad otorgar un accésit dotado con 300 euros a la Delegación de Estudiantes de Medicina de la ULL (DemULL) por el video titulado «Gymkana Universitaria Solidaria ULL», premio recogido durante la ceremonia por la alumna del Grado en Medicina y Presidenta de DemULL, Alexandra Collazo.
En cuanto a los TFG o TFM, el jurado en su caso optó por otorgar por unanimidad el primer premio de 500 euros a cada uno a dos trabajos que obtuvieron idéntica puntuación: “Monedas complementarias: una propuesta de moneda para una urbanización de San Cristóbal de La Laguna”, cuyos autores son Esther Hernández, Florencia Iannuzzi y Nisamar Díaz, todas ellas alumnas del Grado en Economía, y a “VUÉLCA-T: Proyecto de formación para el voluntariado en el municipio de Arafo”, realizado por Rut Martín, alumna del Grado en Pedagogía. Esta estudiante renunció a recibir su premio, que cedió a la asociación Espacio 3.16, aprovechando esa posibilidad que se ofrecía en las bases de la convocatoria.
También se acordó dos accésit de 300 euros cada uno a los siguientes trabajos de fin de grado: “El papel del trabajo social en la cooperación internacional para el desarrollo”, por Nuria Arbelo, alumna de Trabajo Social, y “Resiliencia, significación vital, bienestar subjetivo y apoyo social percibido en Indonesia”, a cargo de Luz Marina García, de la misma titulación.